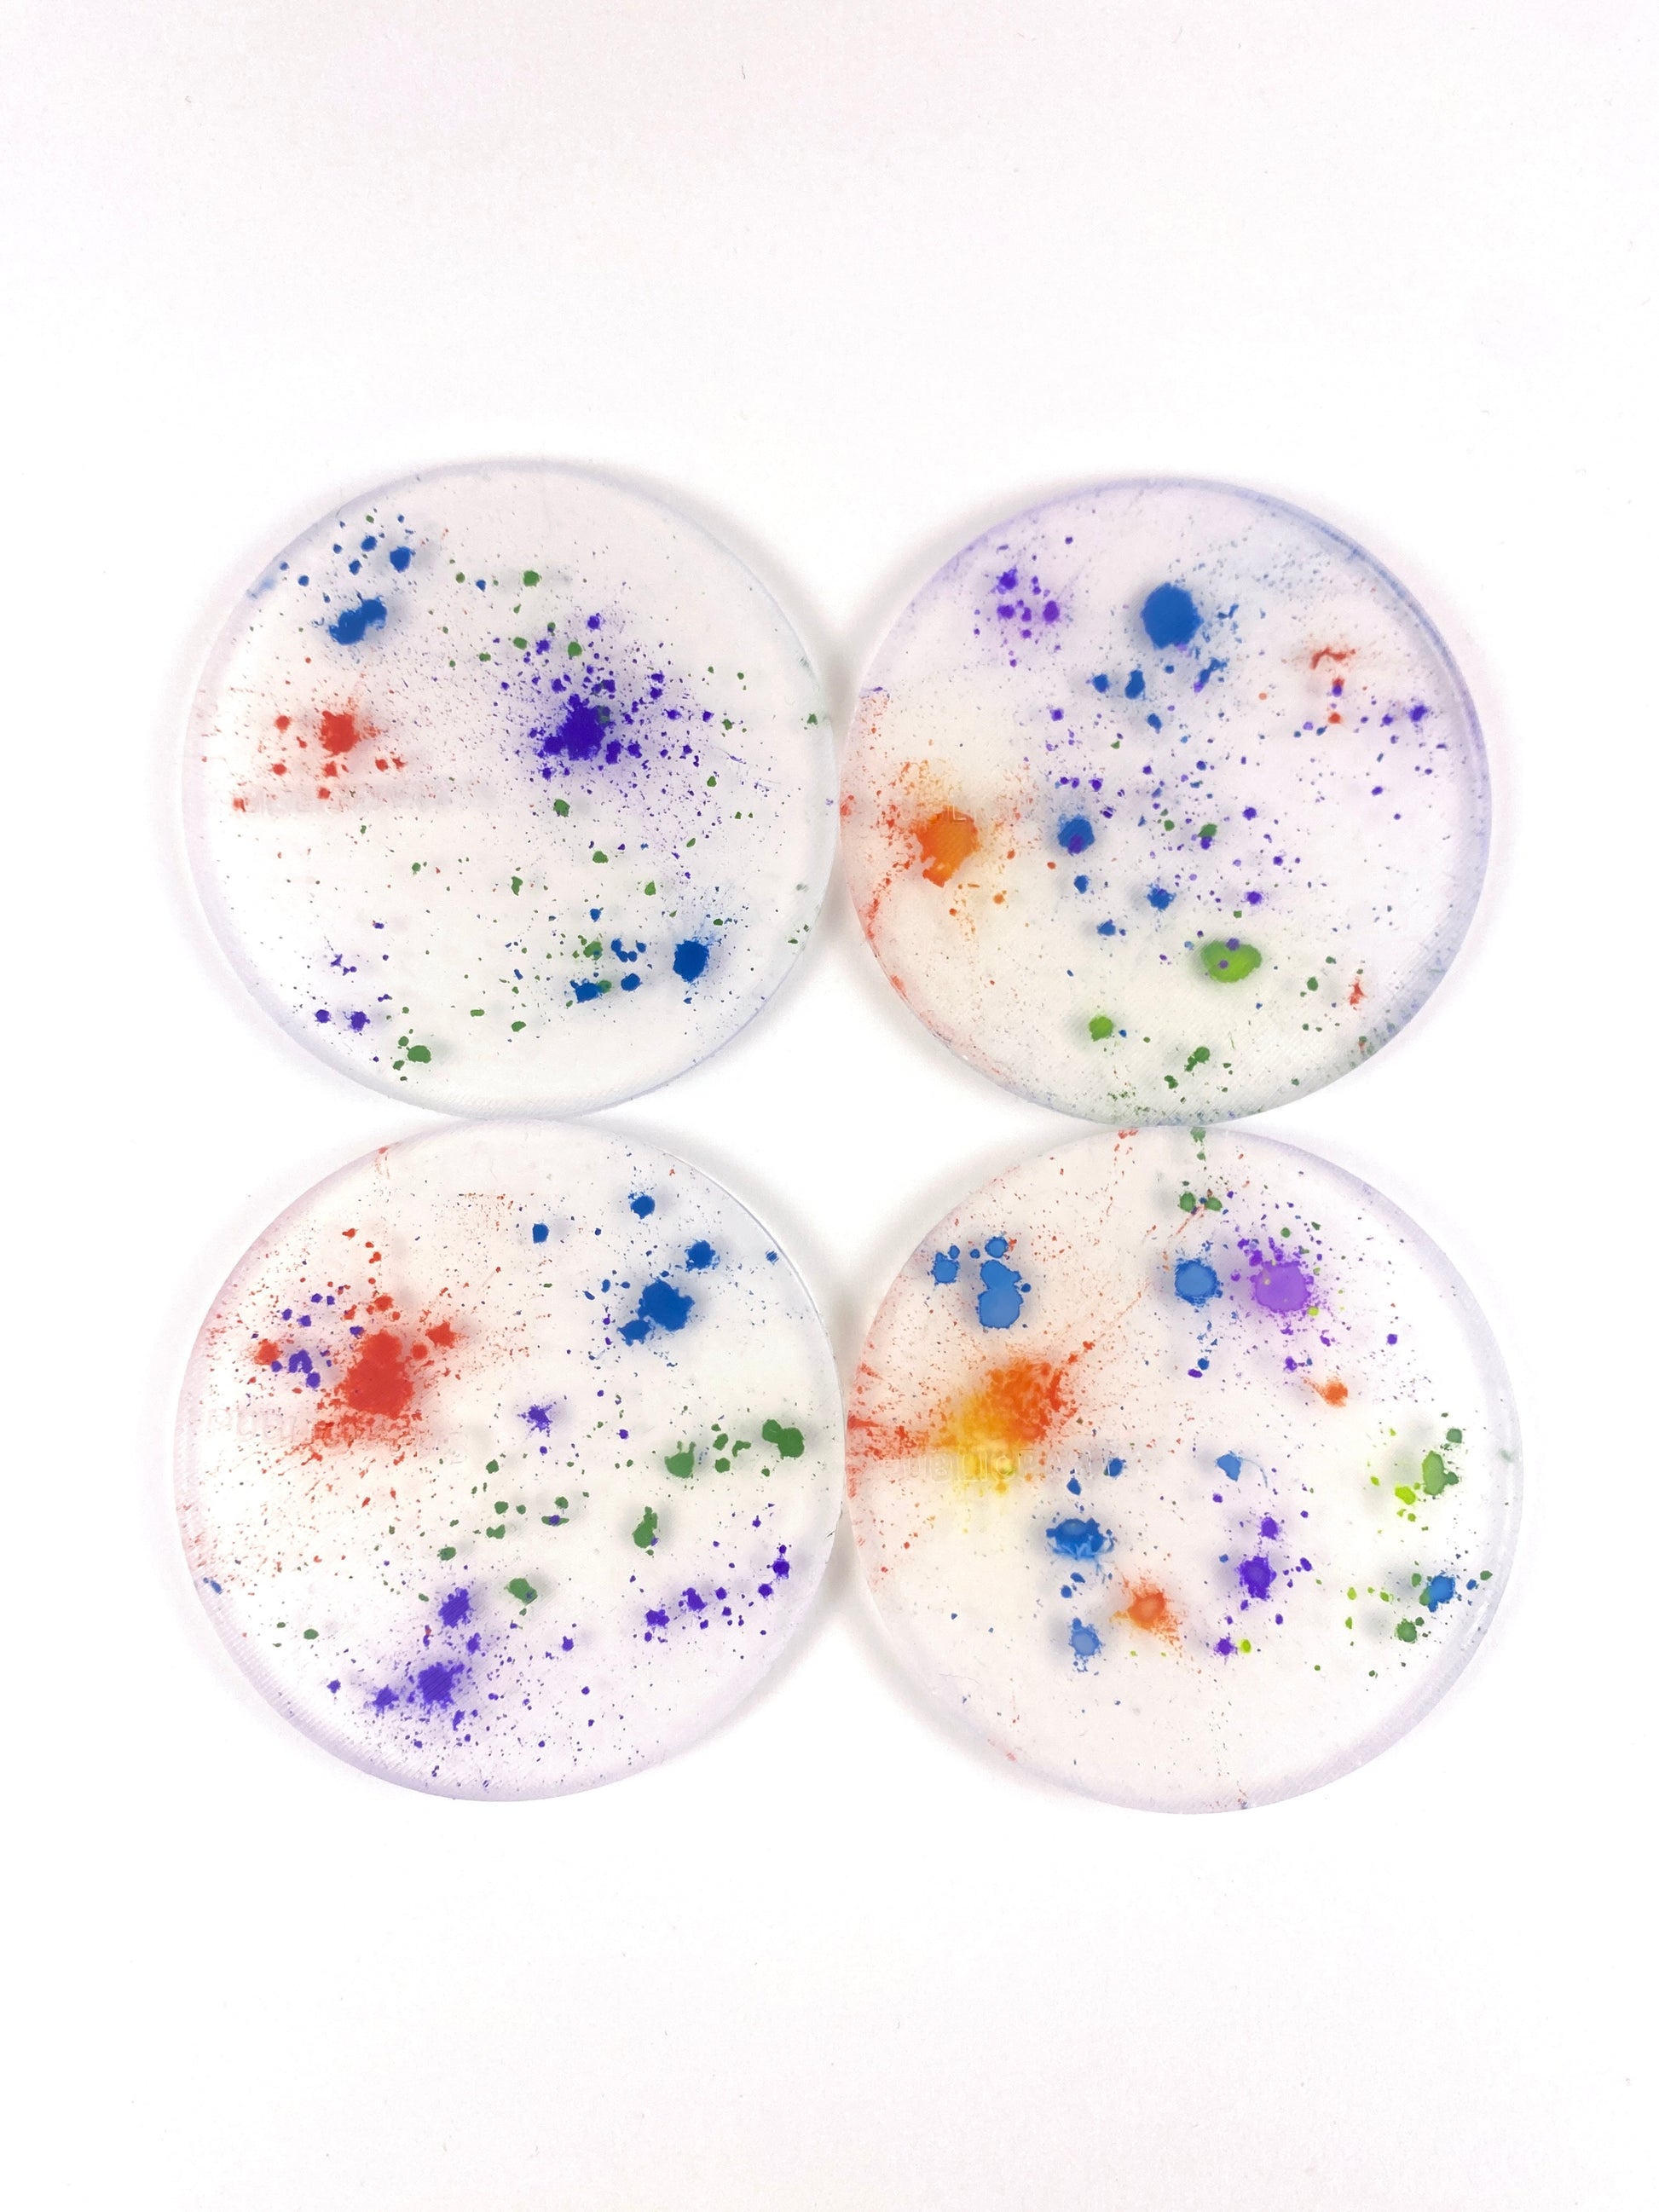
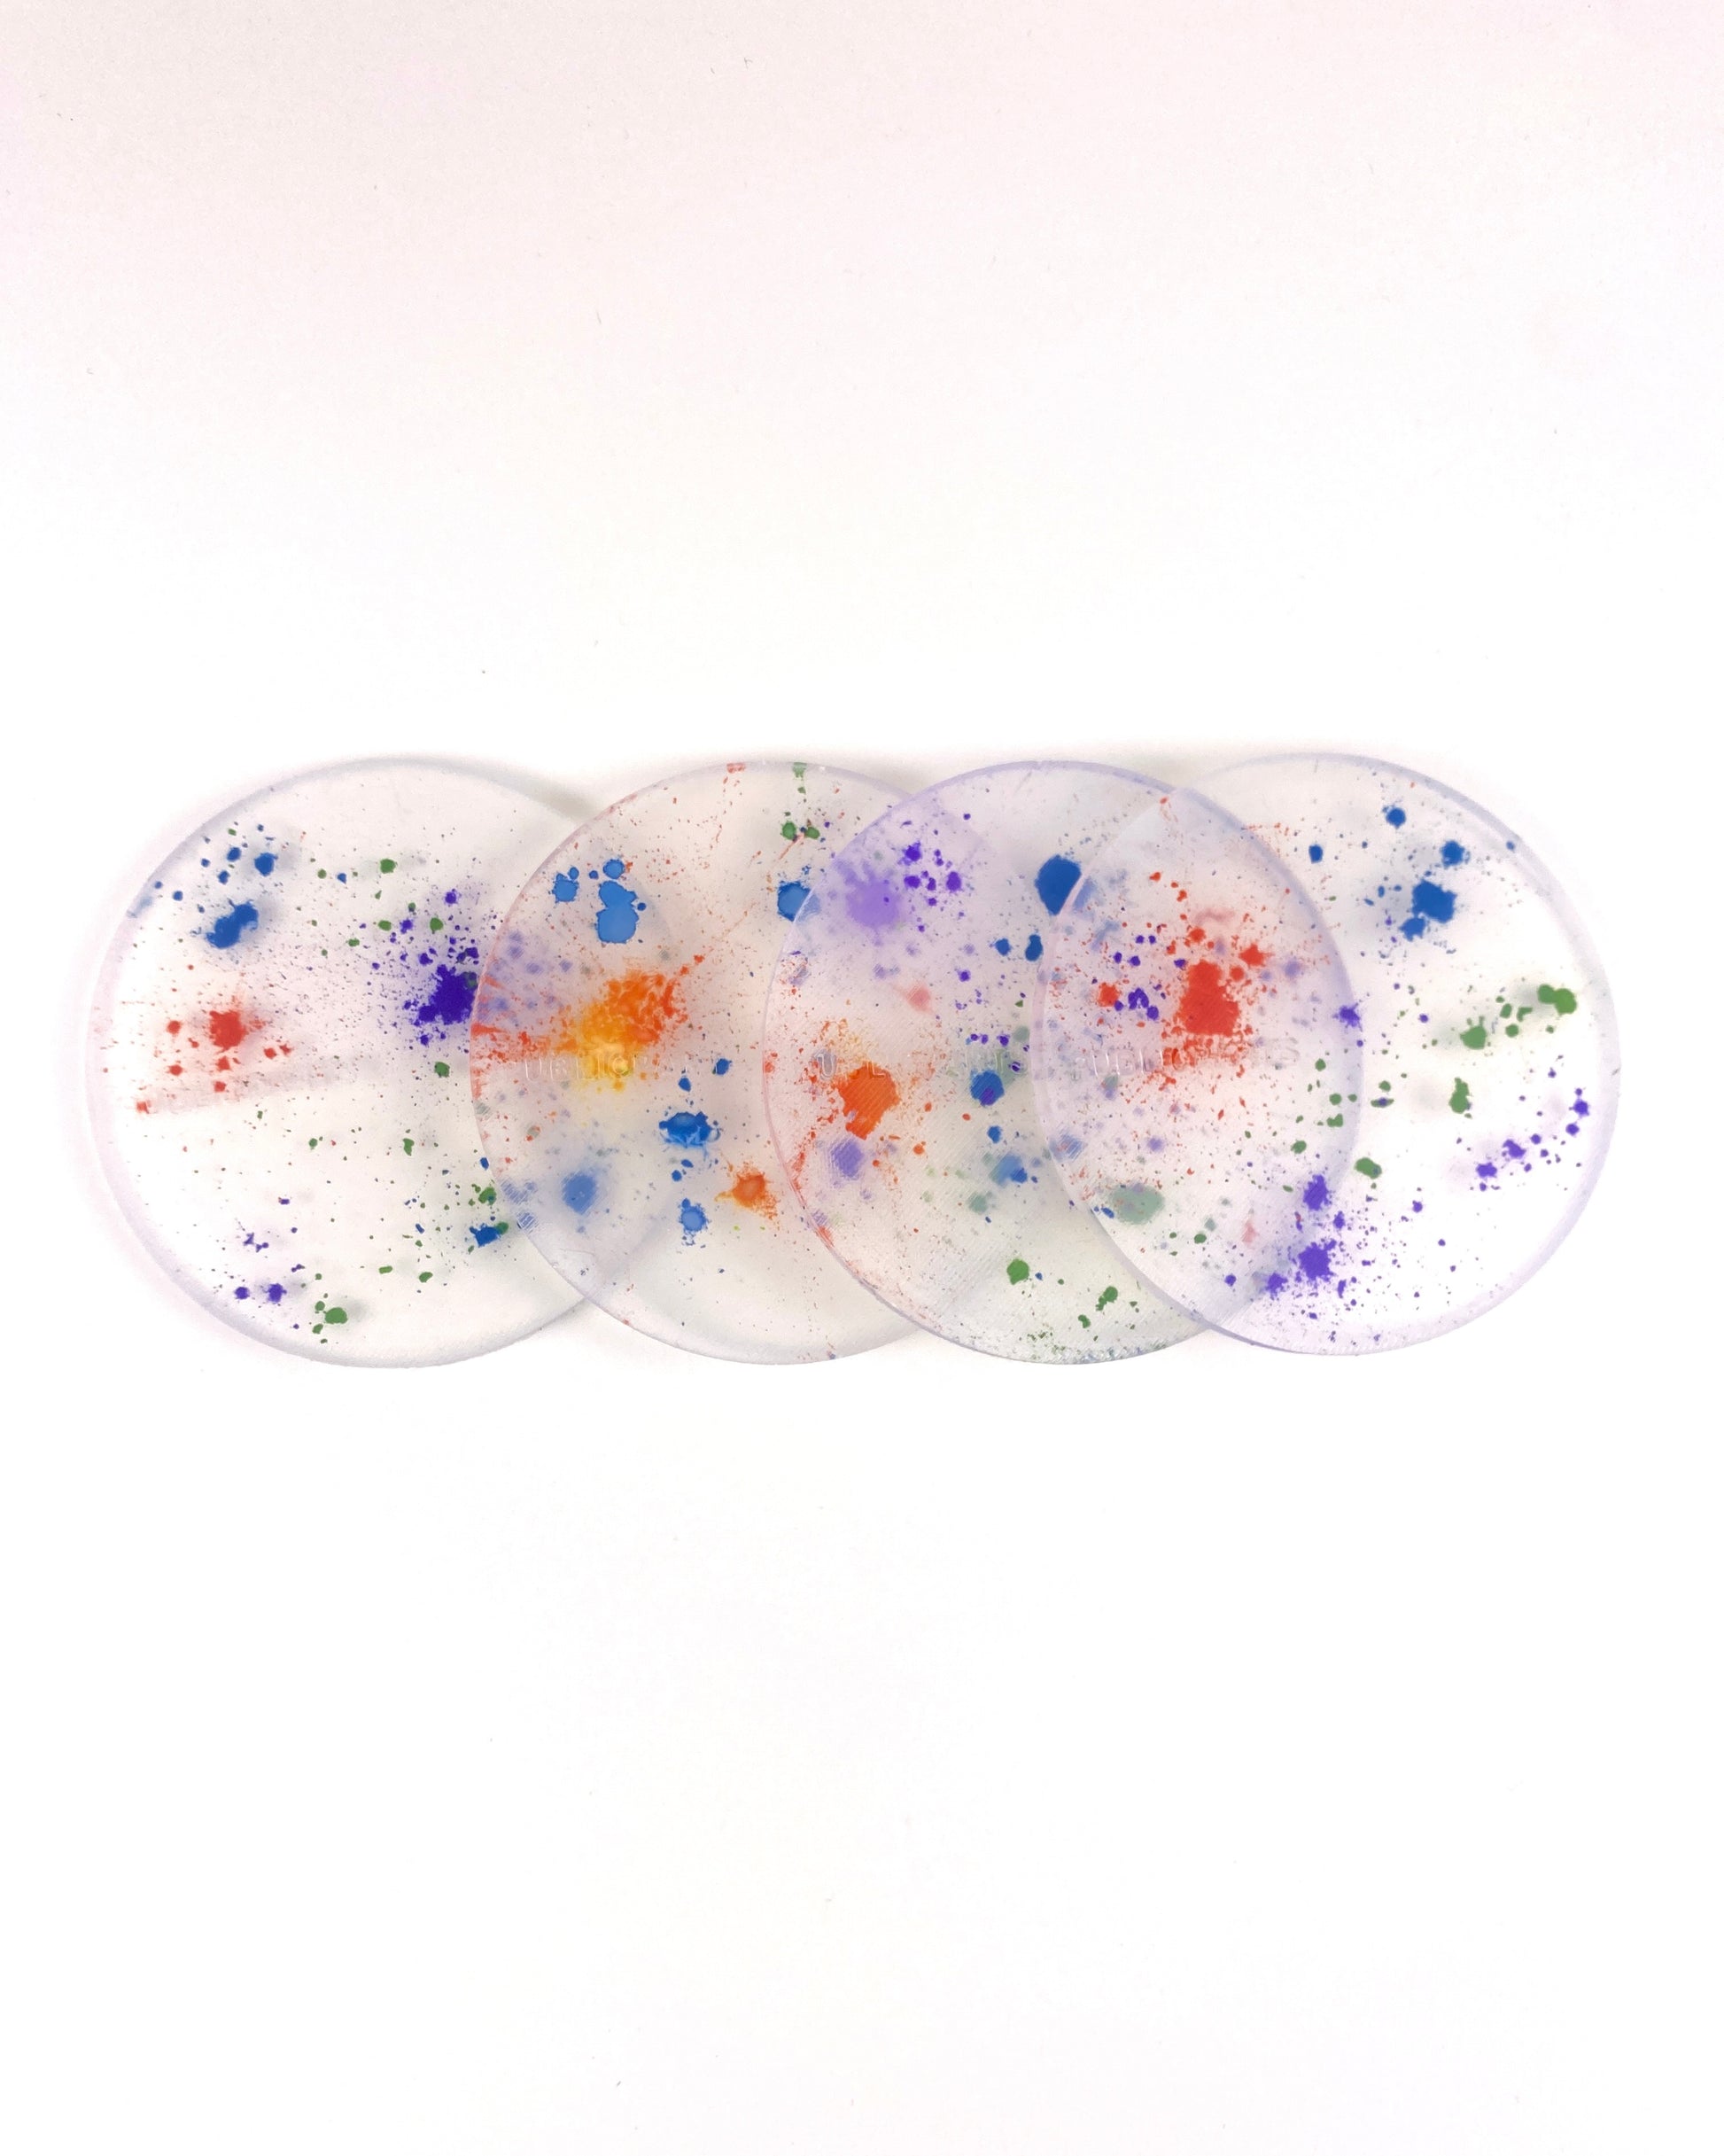
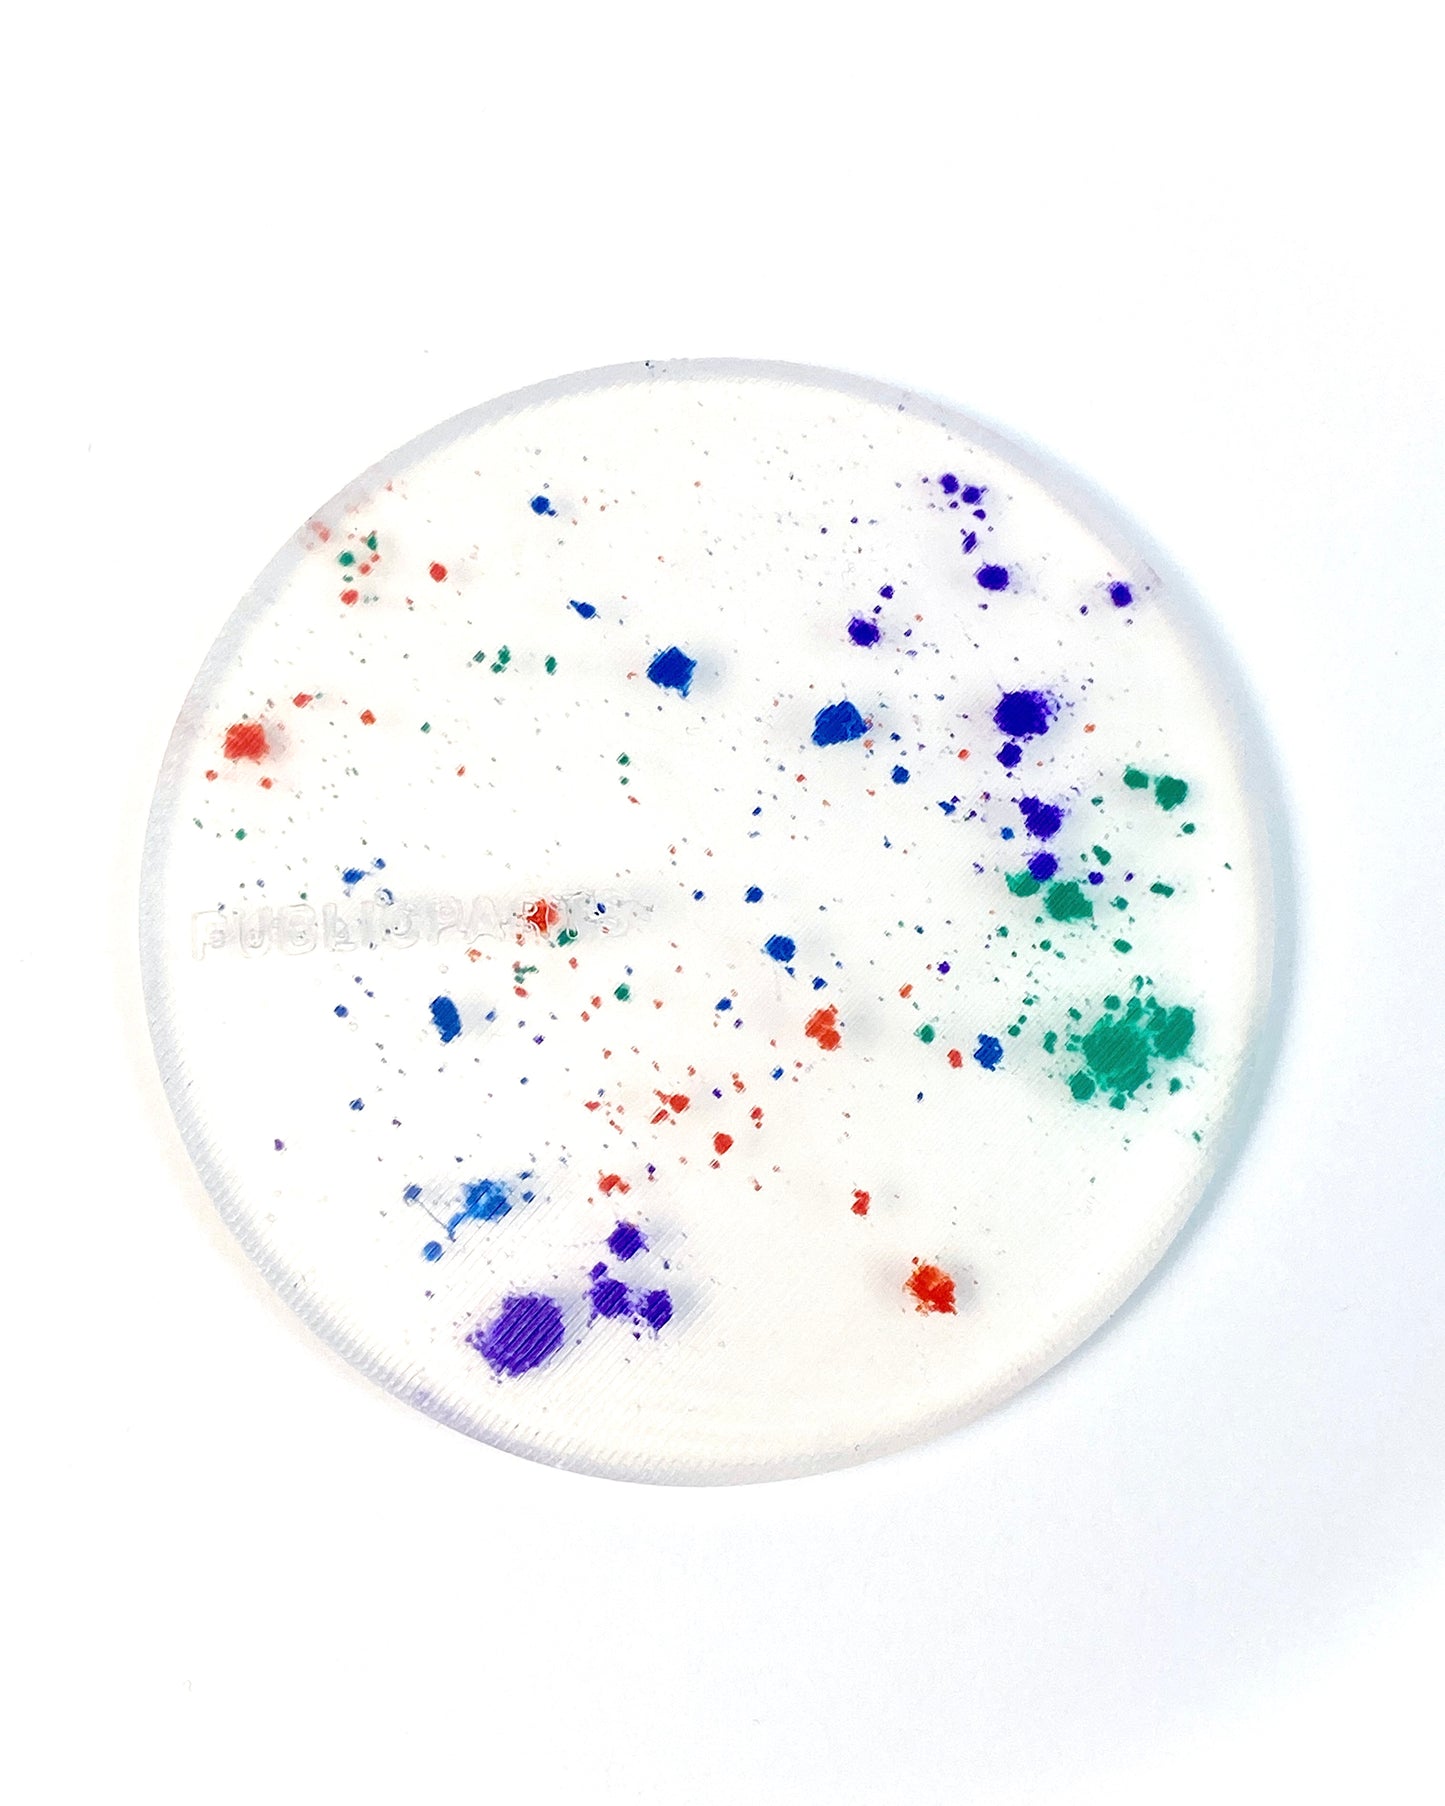
Powder Dust Coaster Set — Set of 4

PUBLICPARTS
Spectra - Powder Dust · Silicone Coaster Set (Heat-Reactive)
Spectra - Powder Dust · Silicone Coaster Set (Heat-Reactive)
Powder Dust Coaster Set — Set of 4
Minimal design meets playful transformation.
Each clear silicone coaster is infused with suspended thermochromic powder that reacts to warmth — shifting tone and revealing delicate bursts of colour beneath the surface.
Hand-poured to order in small batches from premium transparent silicone, every piece is unique, its pattern shaped by an experimental pigment process.
Designed for those who appreciate functional art, these coasters protect your surfaces while introducing a subtle, kinetic element to your space.
Details
• Set of four heat-reactive silicone coasters
• Diameter approx. 9.2 cm
• Made to order and finished in our London studio
• Food-safe, flexible, and easy to clean
• Each piece is one-of-a-kind
Care
Wash with mild soap and water.
Avoid abrasives, sharp objects, and prolonged exposure to direct sunlight.
Part of the PUBLICPARTS Studio range — limited-edition designs exploring material, form, and transformation.
Share